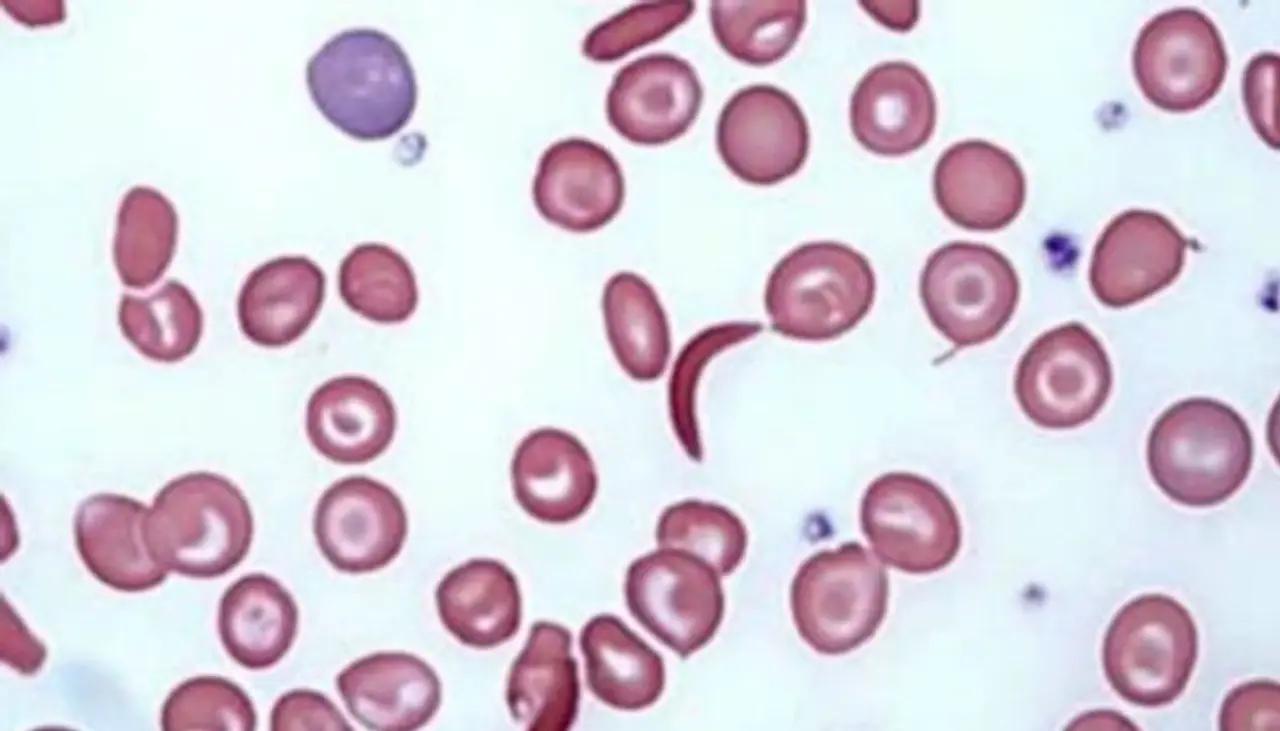

Anemia In Men : ಪುರುಷರಲ್ಲಿ ಅನೀಮಿಯಾ ಸಮಸ್ಯೆ, ಈ ಲಕ್ಷಣಗಳನ್ನು ಇಗ್ನೋರ್ ಮಾಡ್ಬೇಡಿ
ರಕ್ತಹೀನತೆ (anemia )ಮಹಿಳೆಯರಲ್ಲಿ ಮಾತ್ರವಲ್ಲದೆ ಪುರುಷರಲ್ಲೂ ಉಂಟಾಗಬಹುದು. ಇತ್ತೀಚಿನ ರಕ್ತಹೀನತೆಯ ಪ್ರಕರಣಗಳು ಪುರುಷರಲ್ಲಿ ವೇಗವಾಗಿ ಹೆಚ್ಚಿವೆ, ಆದ್ದರಿಂದ ಅದರ ರೋಗಲಕ್ಷಣಗಳನ್ನು ತಿಳಿದುಕೊಳ್ಳುವುದು ಮುಖ್ಯ. ಈ ರೋಗಲಕ್ಷಣಗಳನ್ನು ನೀವು ಗಮನಿಸಿದರೆ, ಅವುಗಳನ್ನು ನಿರ್ಲಕ್ಷಿಸಬೇಡಿ.
ರಕ್ತಹೀನತೆಗೆ ಸಾಮಾನ್ಯ ಕಾರಣವೆಂದರೆ ದೇಹದಲ್ಲಿ ಕಡಿಮೆ ಮಟ್ಟದ ಕಬ್ಬಿಣ (iron). ಈ ರೀತಿಯ ರಕ್ತಹೀನತೆಯನ್ನು ಕಬ್ಬಿಣದ ಕೊರತೆ ರಕ್ತಹೀನತೆ ಎಂದು ಕರೆಯಲಾಗುತ್ತದೆ. ನಿಮ್ಮ ದೇಹದಾದ್ಯಂತ ಆಮ್ಲಜನಕವನ್ನು ಚಲಿಸುವ ವಸ್ತುವಾದ ಹಿಮೋಗ್ಲೋಬಿನ್ ತಯಾರಿಸಲು ನಿಮ್ಮ ದೇಹಕ್ಕೆ ಒಂದು ನಿರ್ದಿಷ್ಟ ಪ್ರಮಾಣದ ಕಬ್ಬಿಣದ ಅಗತ್ಯವಿದೆ. ಅದು ಕಡಿಮೆಯಾದರೆ ರಕ್ತಹೀನತೆ ಸಮಸ್ಯೆ ಕಾಡುತ್ತದೆ.
ರಕ್ತಹೀನತೆಯ ಅನೇಕ ರೂಪಗಳಿವೆ, ಪ್ರತಿಯೊಂದೂ ತನ್ನದೇ ಆದ ಕಾರಣವನ್ನು ಹೊಂದಿದ್ದು. ರಕ್ತಹೀನತೆಯು ತಾತ್ಕಾಲಿಕ ಅಥವಾ ದೀರ್ಘಾವಧಿಯಾಗಿರಬಹುದು. ಸೌಮ್ಯದಿಂದ ತೀವ್ರದವರೆಗೆ ಇರಬಹುದು. ಹೆಚ್ಚಿನ ಸಂದರ್ಭಗಳಲ್ಲಿ, ರಕ್ತಹೀನತೆಯು ಒಂದಕ್ಕಿಂತ ಹೆಚ್ಚು ಕಾರಣ ಹೊಂದಿದೆ. ನಿಮಗೆ ರಕ್ತಹೀನತೆ ಇದೆ ಎಂದು ಅನುಮಾನಿಸಿದರೆ ನಿಮ್ಮ ವೈದ್ಯರನ್ನು ಭೇಟಿಮಾಡಿ. ಇದು ಗಂಭೀರ ಕಾಯಿಲೆಯ ಎಚ್ಚರಿಕೆಯ ಸಂಕೇತವಾಗಿರಬಹುದು.
ಟಿನ್ನಿಟಸ್: ರಕ್ತಹೀನತೆಯು (animea) ಟಿನ್ನಿಟಸ್ ಸಮಸ್ಯೆಗಳನ್ನು ಸಹ ಹೊಂದಿರಬಹುದು. ಇದು ಕಿವಿಗಳಿಗೆ ರಕ್ತದ ಪೂರೈಕೆಯನ್ನು (blood circulation) ಅಡ್ಡಿಪಡಿಸುತ್ತದೆ, ಇದರಿಂದ ಜನರು ಎರಡೂ ಕಿವಿಗಳಲ್ಲಿ ರಿಂಗಣಿಸುವ ಅನುಭವವನ್ನು ಅನುಭವಿಸುತ್ತಾರೆ.
ಕೂದಲು ಉದುರುವಿಕೆ (hair loss): ಕೆಲವೊಮ್ಮೆ ಶಸ್ತ್ರಚಿಕಿತ್ಸೆ, ಗಡ್ಡೆಗಳು ಅಥವಾ ಹೆಮೆರಾಯ್ಡ್ ಗಳು ದೇಹದಲ್ಲಿ ಕಬ್ಬಿಣದ ಕೊರತೆಯನ್ನು ಉಂಟುಮಾಡುತ್ತವೆ. ಇದರಿಂದ ಹಿಮೋಗ್ಲೋಬಿನ್ ಉತ್ಪಾದನೆ ಕಡಿಮೆಯಾಗುತ್ತದೆ. ಈ ಸಂದರ್ಭದಲ್ಲಿ ದೇಹದ ವಿವಿಧ ಭಾಗಗಳಲ್ಲಿ ಉತ್ಕರ್ಷಣಗೊಂಡ ರಕ್ತದ ಸಾಗಣೆ ಕಡಿಮೆಯಾಗಲು ಪ್ರಾರಂಭಿಸುತ್ತದೆ ಮತ್ತು ಕೂದಲು ಉದುರುವಿಕೆ ಉಂಟಾಗುತ್ತದೆ.
ಕಡಿಮೆ ಟೆಸ್ಟೋಸ್ಟೆರಾನ್ ಮಟ್ಟ : ಟೆಸ್ಟೋಸ್ಟೆರಾನ್ ಅಂತಹ ಲೈಂಗಿಕ ಹಾರ್ಮೋನ್ಆ ಗಿದೆ. ದೇಹದಲ್ಲಿ ಕಬ್ಬಿಣದ ಕೊರತೆಯು ಟೆಸ್ಟೋಸ್ಟೆರಾನ್ ಮಟ್ಟವನ್ನು ಕಡಿಮೆ ಮಾಡುತ್ತದೆ. ಇದರಿಂದ ಲೈಂಗಿಕ ಕ್ರಿಯೆ ನಡೆಸುವಾಗ ಸಮಸ್ಯೆ ಉಂಟಾಗಬಹುದು. ಆದುದರಿಂದ ಇದನ್ನು ಕಡಿಮೆ ಆಗದಂತೆ ನೋಡಿಕೊಳ್ಳಿ.
ಕಡಿಮೆ ಫಲವತ್ತತೆ: ಪುರುಷರಲ್ಲಿ ಕಬ್ಬಿಣದ ಕೊರತೆಯು ಫಲವತ್ತತೆಯ (fertility) ಮೇಲೂ ಪರಿಣಾಮ ಬೀರುತ್ತದೆ. ರಕ್ತಹೀನತೆ, ಆಲ್ಕೋಹಾಲ್ ಅಥವಾ ಶಸ್ತ್ರಚಿಕಿತ್ಸೆಯು ದೇಹದಲ್ಲಿ ಕಬ್ಬಿಣದ ಕೊರತೆಯನ್ನು ಉಂಟುಮಾಡಿದಾಗ, ಅದು ಪುರುಷರ ಫಲವತ್ತತೆಯ ಮೇಲೆ ಪ್ರತಿಕೂಲ ಪರಿಣಾಮ ಬೀರುತ್ತದೆ.
ನುಂಗಲು ಕಷ್ಟ: ಡಿಸ್ಫಾಜಿಯಾವನ್ನು ಕಬ್ಬಿಣದ ಕೊರತೆಯ ಕಾಯಿಲೆ ರಕ್ತಹೀನತೆಯ ಲಕ್ಷಣವೆಂದು ಹೇಳಲಾಗುತ್ತದೆ. ಇದು ಪುರುಷರಲ್ಲಿ ರಕ್ತಹೀನತೆ ಮತ್ತು ಡಿಸ್ಫಾಜಿಯಾವನ್ನು ಒಟ್ಟಿಗೆ ಹೊಂದಿರುವುದು ಜಿಇಆರ್ ಡಿ (ಗ್ಯಾಸ್ಟ್ರೋಅನ್ನನಾಳದ ರಿಫ್ಲಕ್ಸ್ ಕಾಯಿಲೆ) ಅಪಾಯವನ್ನು ಹೆಚ್ಚಿಸುತ್ತದೆ.
ಆರೋಗ್ಯ, ಸೌಂದರ್ಯ, ಫಿಟ್ನೆಸ್, ಕಿಚನ್ ಟಿಪ್ಸ್, ಸಂಬಂಧ, ಫ್ಯಾಷನ್, ರೆಸಿಪಿ ಅಪ್ಡೇಟ್ಗಳಿಗಾಗಿ ಏಷ್ಯಾನೆಟ್ ಸುವರ್ಣ ನ್ಯೂಸ್ ಫಾಲೋ ಮಾಡಿ. ಸಂಪೂರ್ಣ ಮಾಹಿತಿ ಒಂದೇ ಕ್ಲಿಕ್ನಲ್ಲಿ ಲಭ್ಯ. ಏಷ್ಯಾನೆಟ್ ಸುವರ್ಣ ನ್ಯೂಸ್ ಅಧಿಕೃತ ಆ್ಯಪ್ ಡೌನ್ಲೋಡ್ ಮಾಡಿ ಹಾಗು ಎಲ್ಲಾ ಅಪ್ಡೇಟ್ ಗಳನ್ನು ಪಡೆಯಿರಿ.